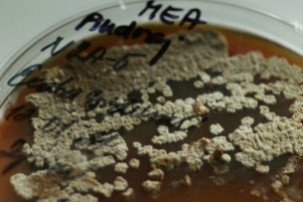

Houby považuje za značně opomíjené organismy, které ale v životě člověka hrají velmi důležitou roli. Věnuje se jim už celé desetiletí. Před pár týdny, koncem listopadu, se Adéla Čmoková stala hlavní autorkou článku v časopise Fungal Diversity, který se zabývá kožními onemocněními způsobenými houbami „dermatofytózami“ přenášenými na člověka ze zvířat.
„Houby nás opravdu obklopují téměř všude,“ prohlašuje na úvod, snad na uklidnění křehká tmavovláska, které tyto organismy učarovaly už v době bakalářských studií. Dnes je Ph.D. studentkou na Katedře botaniky Přírodovědecké fakulty UK a zároveň vědkyní v Mikrobiologickém ústavu Akademie věd ČR. Právě tam, do laboratoří, nechala magazín Forum nahlédnout.
Kudy vedla vaše cesta k vědecké kariéře?
Touha stát se vědkyní byla ve mně vždycky. Jen jsem měla pocit, že věda je „cosi“ vyhrazeného geniálním lidem. Až později jsem pochopila, že je otevřená všem. Pak už jsem jen zvažovala, zda budu bádat v oboru chemie či biologie. Rozhodnutí padlo po Dni otevřených dveří na Přírodovědecké fakultě UK. Byla jsem uchvácena nezdolným nadšením mých současných kolegů a spolupracovníků právě pro biologii. Zvláště profesorem Janem Černým a jeho „kouzlením“ s fluorescenčním mikroskopem. Volba padla sice na biologii, ale dneska se pozvolna k té chemii zase vracím přes houbové metabolity. A vlastně od samého počátku, od prváku, jsem věděla, že chci dělat houby; to mi zůstalo. Bylo jen na mě, který směr si vyberu, kudy se na houby vydám, jakému výzkumu se budu věnovat.
Že jsem se rozhodla správně, o tom jsem dnes naprosto pevně přesvědčena. I z pohledu dopadu hub na člověka a s přihlédnutím na skutečnost, jak málo se studují, bych neměnila. Vždyť téměř každá naše opublikovaná studie má okamžitě obrovský ohlas. Houby nás obklopují, mají nezastupitelnou roli v ekosystému, jsou významnými patogeny – člověka i kulturních rostlin, producenty biotechnologicky významných látek a léčiv. Houby jsou zkrátka po vědecké stránce velice přitažlivé (s úsměvem).
Váš zatím poslední výzkum se týká přenosu patogenních hub z domácích mazlíčků na člověka.
Někdy v roce 2011 začal Vít Hubka (vědec laboratoře genetiky hub Mikrobiologického ústavu AV ČR a mykolog na Katedře botaniky PřF UK – pozn. red.), můj školitel, shromažďovat kmeny dermatofytů, tedy hub způsobujících u lidí a zvířat zánětlivá kožní onemocnění. Během svého pozorování zjistil strmý nárůst výskytu druhů způsobujících dermatofytózy u dětí. Podařilo se mu prokázat souvislost mezi kožním onemocněním dítěte a tím, že se v jeho domácnosti vyskytuje morče. Do té doby se o dermatofytózách morčat příliš nevědělo. Mluvilo se především o kožních onemocněních získaných od psů a koček. Vítek si vlastně v té době nedokázal vysvětlit, proč si tohoto patogena morčat předtím nikdo moc nevšímal. Na tuhle otázku jsme dokázali odpovědět až v naší současné studii.
Patogen se k nám pravděpodobně rozšířil ze zahraničí. Nejspíše ze Severní Ameriky, tamní populace jsou značně diverzifikované, zatímco v Evropě je pouze jeden klon. Bohužel, severoamerický původ nemůžeme s jistotou potvrdit, protože máme k dispozici pouze pár kmenů, není tak v našich silách podchytit celou populaci. Spojili jsme se proto s americkými odborníky a poprosili je o dodatečný sběr materiálu.
A ti „jdou“ po morčatech v domácnostech?
Právě že ne. V Severní Americe má tento patogen zcela odlišného hostitele. Tam jde o dermatofytózy psů. Zvýšený výskyt mykóz přenášených z morčat na děti se týká především střední Evropy, ale poslední data ukazují, že k šíření dochází i mimo Evropu. Týká se například i Japonska, kde je chov drobných hlodavců velmi oblíben... a tudíž rozšířen.
Úkolem studie tedy bylo prokázat původ epidemie?
Zjistili jsme, že se k nám podařilo zanést a rozšířit jeden kmen tohoto patogenu, který je mnohonásobně virulentnější než kmeny, jež byly v Česku rozšířené na morčatech ještě před ním. A dokonce, že nejde o tentýž druh houby. Dokázali jsme rovněž jednotlivé původní evropské druhy popsat.
A „moje“ studentka Lenka Machová (vpravo na společné horní fotografii) , která se problematice věnuje v rámci doktorátu na Katedře genetiky a mikrobiologie PřF UK, ve svých studiích hledala odpověď na otázku: proč právě tento kmen a co je za tím, že je tak „úspěšný“ v přenosu oproti blízce příbuzným evropským druhům.
Díky Lenčině studii už třeba víme, že virulentnější kmen je kupříkladu odolnější vůči stresu ze strany hostitele. A že navíc produkuje, řekněme, zajímavé těkavé látky.
Aha, takže by se dalo říct, promiňte mi: že je váš výzkum cítit?
Přesně tak. „Naše“ houby mají specifický odér. Když si k nim čichnete, tak je to opravdu dost hrozné! (směje se). Ještě třeba dvě hodiny po našem odchodu z laboratoře je znát, že jsme tam se vzorky pracovali. Ani jsme Petriho misky nemuseli otevírat, tak silné jsou a difundují, pronikají do svého okolí. Jde o součást našeho výzkumu, o výzvu pro nejbližší období: rádi bychom dokázali identifikovat patogenní houby přenosné ze zvířat na člověka právě podle pachu.
Existují přístroje, říká se jim elektronické nosy, do nichž je možné „nahrát“ látky, které znáte a které chcete vysledovat. Pak zařízení k nakaženému člověku jen přiložíte a během několika sekund se dozvíte, zda je daná osoba houbou postižena.
Diagnostikování kmenů mykóz asi není úplně snadné, že?
Je to velmi obtížné, jsou si totiž morfologicky hodně podobné. Dermatologům by velmi pomohlo, kdyby se podařilo jednotlivé druhy identifikovat.
A co morče, pozná se na něm, že je hostitelem patogenní houby?
Výskyt toho „našeho“ kmene, tedy Trichophyton benhamiae, který dermatofytózy způsobuje, se rozhodně nepozná. Jde kolikrát o bezpříznakové onemocnění ukryté v kožíšku zvířete, aniž by to vědělo. Zkrátka si s hostitelem vytvoří něco jako vzájemně tolerovaný vztah. Ovšem v momentě přenosu na člověka, vyvolá zánětlivou reakci. Ta se naštěstí velmi brzy dá bez následků odhojit. Bez odborné pomoci to často ale nejde. Možná se právě v tomto čase ordinace kožních lékařů plní pacienty ještě více než kdy jindy: spousta dětí si přála najít pod vánočním stromečkem morčátko…
Prozraďte, prosím, něco více o vaší vědecké skupině.
Nese jméno Onygenales Working Group a nyní se do jejího čela dostal Vít Hubka. Tato skupina sdružuje desítky lidí ze všech koutů světa. Jak jsem již naznačila, výzkum probíhá na mezinárodní úrovni. Pořádáme různé workshopy a díky tomu můžeme stále udržovat kontakt se svými zahraničními kolegy a určovat směr výzkumu. Například díky kolegům z USA jsme se v minulosti dostali k tamním psím vzorkům a teď třeba popisujeme další nové druhy v Íránu.
A co vás čeká v nebližší době?
Letos máme před sebou vyhodnocení velké epidemiologické studie. Během deseti let jsme zjišťovali spektrum patogenů způsobujících dermatofytózy. Získali jsme velké množství kmenů, které sloužily jako základ pro studium genetické diverzity komplexu druhů příbuzných T. benhamiae. Zapojila se řada klinických pracovišť napříč Českou republikou. A díky mezinárodní spolupráci se nám výsledky daří začlenit do širších souvislostí.
Na závěr se vás, Adélo, nemohu nezeptat: máte doma morče?
Mívávala jsem. Teď už si vystačím s laboratorními modely. Nám k výzkumu stačí vzorek kůže, který je udržován ve vitálním stavu. Aktuálně právě Lenka plísně očkuje na kožní štěpy.
Ale přesně jako vy, stejnou otázku by měl položit i doktor, do jehož ordinace přijde pacient s mykózou. Měl by se zeptat nejen na kočku a psa, ale také na morče či dokonce ježka v domácnosti. Léčbu by to ohromně urychlilo. Dříve totiž neměl nikdo ani zdání, že právě morčecí domácí mazlíček může představovat riziko (fotografie z Akademie věd ČR zachycují, jak se mohou u dítěte projevit infekce patogenem morčat Trichophyton – pozn. red.).
Rozhovor končí, vypínám diktafon. „Prosím, jen aby to nevypadalo, že za všechno mohou morčata! Říká se, že zhruba čtvrtina populace je postižena nějakou dermatofytózou. Ovšem nejčastěji se jedná o plísně, které si lidé předávají vzájemně mezi sebou, a v těch jsou morčata naprosto nevinně,“ klade mi na srdce a upřesňuje vědkyně, jež se houbám věnuje i ve svém volném čase – studuje sekundární metabolity hub.
| Mgr. Adéla Čmoková |
| Pochází z Prahy. Po maturitě na Gymnáziu Elišky Krásnohorské GEKOM pokračovala ve studiích na Přírodovědecké fakultě UK. Již během prvního ročníku v oboru Molekulární biologie a biochemie organismů začala pracovat v Mikrobiologickém ústavu AV ČR, kam ji zlákal její pozdější školitel MUDr. Mgr. Vít Hubka, Ph.D.: „Na Vítkovi je vidět, jak ho vědecká práce nesmírně baví a s jak ohromnou touhou jde po nových informacích. Je neuvěřitelně cílevědomý a pracovitý. Zkrátka neobyčejně inspirativní šéf – kolega!“ |